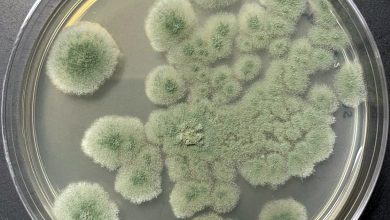

Балаковские студенты прошли «огонь, воду и разборку АК» на спартакиаде
В Балаково завершилась трехдневная Спартакиада молодежи допризывного возраста, посвященная памяти Героя Советского Союжа Валентина Кирилловича Ерошкина. Участниками стали юноши 2009–2011…
Следователям СК в Балаково вручили первые погоны лейтенантов юстиции
В следственном управлении Следственного комитета России по Саратовской области состоялось торжественное мероприятие, посвященное присвоению специальных званий. Знаковым событием стало получение…
В Балаково увековечат подвиг героя Беслана: появится скульптура Вячеслава Малярова
В городе планируют установить памятник земляку – офицеру группы «Альфа» Вячеславу Малярову, ценой своей жизни спасавшему детей во время теракта…
В Балаково молодая женщина сбила девочку-велосипедистку на «зебре»
Как сообщает пресс-служба МУ МВД России «Балаковское», накануне в городе произошло дорожно-транспортное происшествие с участием ребенка, которое привлекло особое внимание…
Богатые россияне массово покупают убежища в Новой Зеландии на случай ядерной войны
Обеспеченные россияне активно скупают жильё с бункерами в Новой Зеландии, рассматривая её как убежище на случай глобального военного конфликта. Об…
Ветераны МВД Балаково получили награды и знаки «За особые заслуги»
В музее истории милиции МУ МВД России «Балаковское» прошло торжественное мероприятие, посвященное Дню ветерана органов внутренних дел. В зале, где…
В Балаково на «Зарнице 2.0» определили сильнейших: гимназия №2 взяла золото
На базе школы №16 отгремел финал муниципального этапа Всероссийской военно-патриотической игры «Зарница 2.0». Сегодня за звание лучших в старшей возрастной…
Многоликая гитара: классика и драйв электрогитары сразятся на сцене в ГЦИ Балаково
26 апреля в 16:00 Городской центр искусств Балаково превратится в эпицентр струнной магии. Здесь состоится концертная программа «Многоликая гитара», которая…
Врачи Балаково извлекли из пищевода ребёнка опасный сувенир из магазина
Очередной случай детского любопытства едва не закончился трагедией в Балаковской городской клинической больнице (БГКБ). Заведующая эндоскопическим отделением Элла Анатольевна Бобрышева…
Киберполиция и полиция Балаково предупреждают: новая схема с «висящими» объявлениями
Злоумышленники нашли способ обманывать граждан, используя их же старые, давно закрытые объявления. В зоне риска – все, кто когда-либо пользовался…